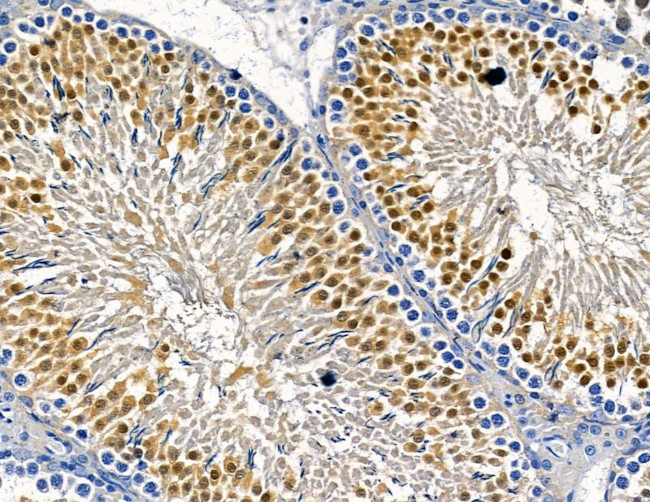
IFI35 Antibody in Immunohistochemistry (Paraffin) (IHC (P))

Search
Invitrogen
IFI35 Polyclonal Antibody
{{$productOrderCtrl.translations['antibody.pdp.commerceCard.promotion.promotions']}}
{{$productOrderCtrl.translations['antibody.pdp.commerceCard.promotion.viewpromo']}}
{{$productOrderCtrl.translations['antibody.pdp.commerceCard.promotion.promocode']}}: {{promo.promoCode}} {{promo.promoTitle}} {{promo.promoDescription}}. {{$productOrderCtrl.translations['antibody.pdp.commerceCard.promotion.learnmore']}}
图: 1 / 3
IFI35 Antibody (PA5-100837) in IHC (P)



Please note: We are reviewing Western blot images included in the antibody testing data in our catalog, including those provided by third parties. Unless expressly labeled or annotated as “raw-unedited”, Western blot images included in the antibody testing data in our catalog may have been edited, optimized or otherwise adjusted for presentation.
产品信息
PA5-100837
种属反应
宿主/亚型
分类
类型
抗原
偶联物
形式
浓度
规格
纯化类型
保存液
内含物
保存条件
运输条件
RRID
产品详细信息
Antibody detects endogenous levels of total IN35.
靶标信息
Interferon-Induced Protein 35 (IFI35), encoded by the IFI35 gene, is located on chromosome 17 and is recognized for its role in immune response modulation, especially under viral stress conditions. Structurally, IFI35 is part of a complex regulatory network that influences non-canonical NF-kB signaling. This process involves the proteasomal processing of p105 into the DNA-binding transcription factor p50, which forms a heterodimer with RELB (RELB/p50) to activate cell chemotaxis autonomously. The gene's dynamic expression under viral stress has been linked to various immune regulatory networks and is crucial for immune cell recruitment and maintenance, particularly M2-like tumor-associated macrophages (TAMs) within the tumor microenvironment. IFI35 upregulation is significant in conditions of neuroinflammation and multiple sclerosis, especially in patients treated with interferons (IFN), indicating its potential as a biomolecular marker. Additionally, IFI35's role in triple-negative breast cancer highlights its impact on antitumor immunity, where its ablation enhances the infiltration of effector CD8+ T cells and sensitizes tumors to anti-PD-1 immunotherapy. This positions IFI35 as a key player in both immune response and cancer treatment strategies.
仅用于科研。不用于诊断过程。未经明确授权不得转售。